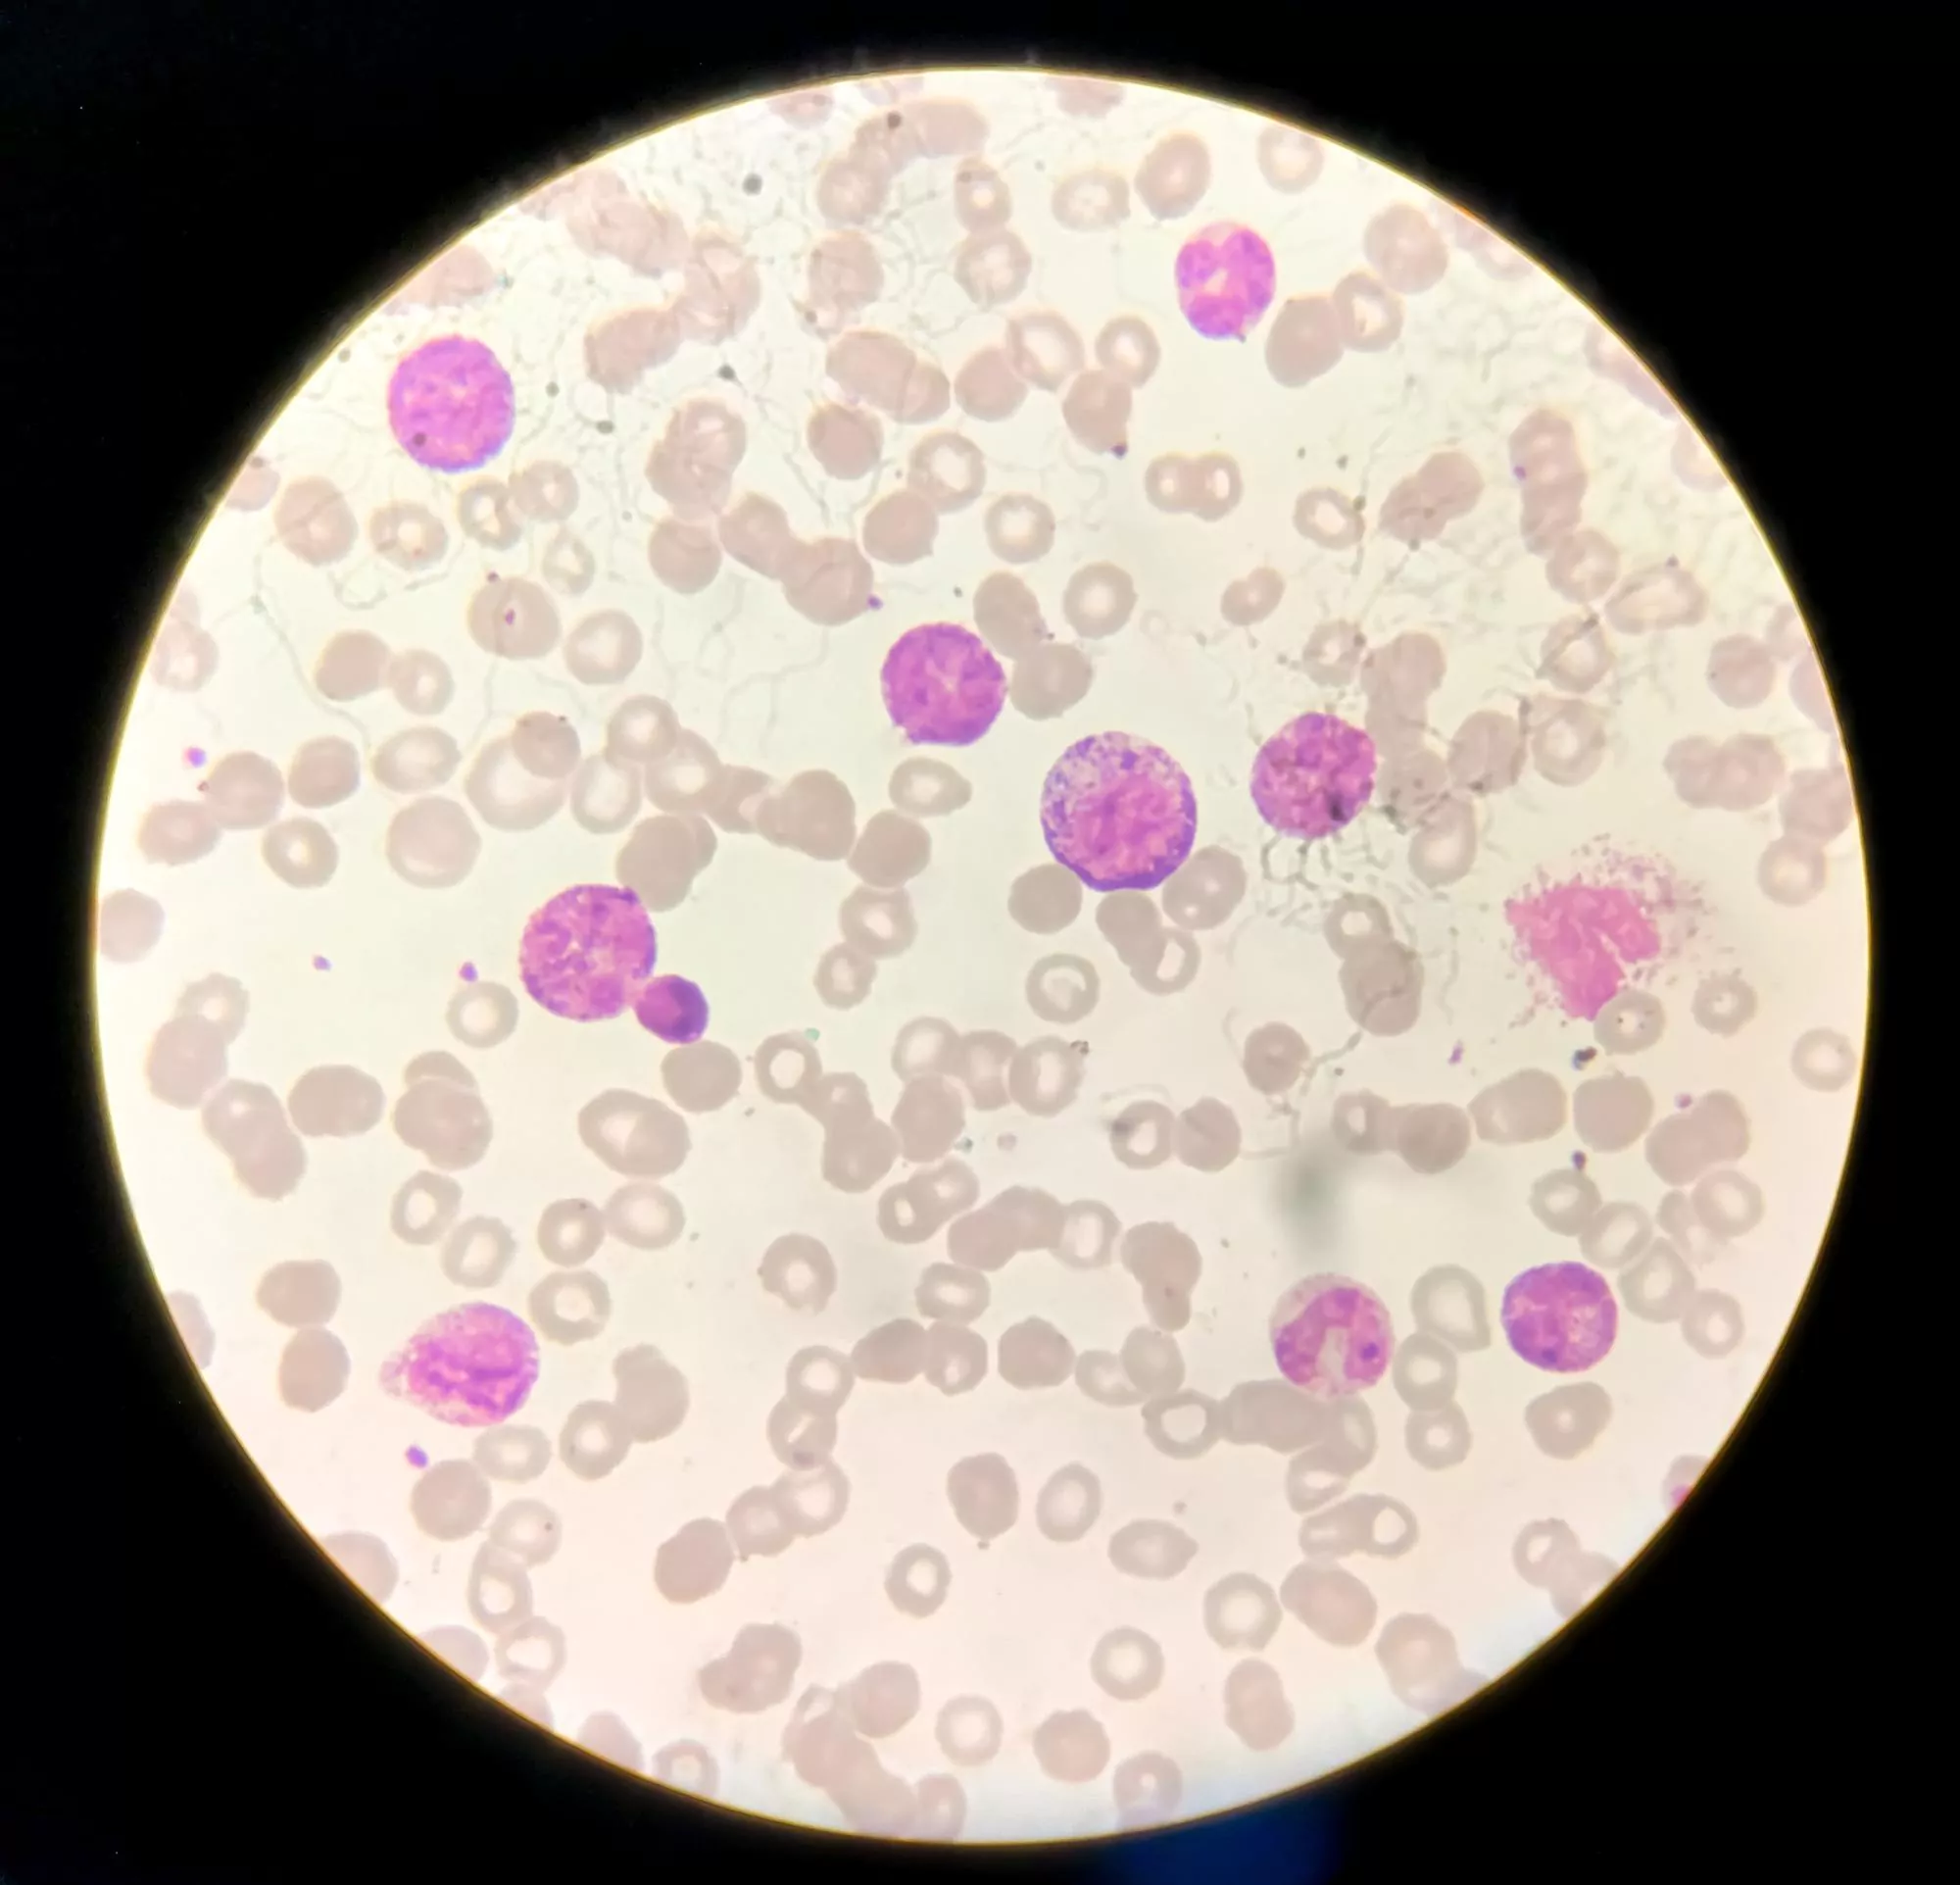
CML

Chronic Myeloid Leukaemia (CML) is a type of cancer that affects the blood and bone marrow. In CML, the bone marrow produces too many white cells, called granulocytes. These cells, sometimes called blasts or leukaemic blasts, gradually crowd the bone marrow, interfering with normal blood cell production.
CML typically develops gradually at first, hence the term ‘chronic’, and can progress into a more aggressive type, known as ‘acute’ or ‘blast phase’ CML, if not treated. This condition is generally seen in adults and is rarely seen in children.
Patients diagnosed with CML often have an abnormal chromosome called the Philadelphia chromosome, which involves an exchange of DNA between chromosome 9 and 22. This results in an oncogene called BCR-ABL, which leads to the overproduction of white blood cells.

CML can lead to fatigue, weakness, and other signs of anaemia due to a lack of red blood cells, fever, night sweats, and splenomegaly or enlargement of the spleen caused by an excessive number of white cells in the spleen.
The treatment of CML has significantly improved in recent years, especially with the introduction of tyrosine kinase inhibitors (TKIs) such as Imatinib, Nilotinib, and Dasatinib. These drugs target the BCR-ABL protein, effectively limiting the proliferation of leukemic cells.
Causes of Chronic myeloid leukaemia
Chronic myeloid leukaemia (CML) is a type of cancer that affects the blood and bone marrow. CML occurs when something goes awry in the genes of your blood cells.
The main cause of CML is a gene mutation called the Philadelphia chromosome. This mutation happens when chromosomes 9 and 22 break and swap some genetic material. The new chromosome 22 contains a gene called BCR-ABL, a gene that produces an enzyme known as tyrosine kinase. This enzyme promotes the excessive growth of white blood cells, leading to CML.
Despite this understanding, it’s not clear what causes this genetic alteration. It’s not inherited, but appears randomly in people. It can occur at any age, but it’s more common in older adults.
Factors like exposure to high doses of radiation can increase the likelihood of developing CML but in majority of the cases, there’s no identifiable risk factor.
The diagnosis of CML often happens during a routine blood test or after the person has started showing symptoms like fatigue, weight loss, pain on the left side of the abdomen (from an enlarged spleen), night sweats or fevers. Further tests like a bone marrow test is often used to confirm a diagnosis of CML.
Risk Factors of Chronic myeloid leukaemia
Chronic myeloid leukaemia (CML) is a type of cancer that affects the blood-forming cells of the bone marrow. While the exact causes are unknown, several risk factors are associated with the development of CML:
1. Age: CML can occur at any age, but it tends to affect older adults more.
2. Gender: Men are slightly more likely to develop CML than women.
3. Radiation Exposure: Exposure to high-dose radiation, such as those from a nuclear reactor accident or atomic bomb, increases the risk of CML. Low-dose exposure, like from X-rays, has not been definitively linked to CML.
4. Genetic Factors: The presence of the Philadelphia chromosome, a genetic abnormality found in most persons with CML, is a significant risk factor, although it’s unclear why some people with this abnormality develop leukemia while others do not.
5. Other risks: Certain blood disorders and chemical exposures have been suggested as possible risk factors for CML, but clear links have not been established.
Please note that having one or more of these risk factors does not necessarily mean that a person will develop CML. It’s important to discuss any concerns with a healthcare provider.
Signs and Symptoms of Chronic myeloid leukaemia
Chronic Myeloid Leukemia (CML) is a type of cancer that affects the blood and bone marrow. In CML, the bone marrow produces too many white blood cells.
Symptoms of CML can be varied and, in the early stages of the disease, you may not experience any symptoms at all. In fact, a diagnosis is often discovered during routine blood tests before symptoms start showing. However, as the disease progresses, symptoms may begin to appear.
Possible signs and symptoms include:
1. Feeling very tired and fatigue: This is due to the lack of healthy red blood cells in your body, which are responsible for delivering oxygen to your tissues.
2. Weight loss without trying: You may lose weight without making any changes to your diet or physical activity.
3. Pain or fullness below the ribs on the left side: This is the result of an enlarged spleen, which is the body’s response to an excess of white blood cells being removed from circulation.
4. Excessive sweating during sleep (night sweats): This could be caused by the disease or related issues such as fever.
5. Fever: Higher than normal body temperature, often a sign that the body is fighting off some type of infection or illness.
6. Easy bruising or bleeding: This occurs due to a decrease in platelets which help in blood coagulation.
7. Frequent infections: Because CML affects your immune system, it compromises your ability to fight off infections.
8. Shortness of breath: As a result of fewer red blood cells to carry oxygen.
Remember, having one or more of these symptoms does not definitely mean you have CML. These symptoms could be signs of other health conditions too. It is advisable to consult a healthcare professional if you experience these symptoms persistently.
Diagnosis Chronic myeloid leukaemia
Chronic myeloid leukaemia (CML) is a type of cancer that affects the blood and bone marrow. In CML, the bone marrow produces too many white blood cells. These abnormal cells crowd out the healthy cells and interfere with normal blood function.
CML is characterized by the presence of a genetic mutation called the Philadelphia chromosome. This mutation occurs when pieces of chromosome 9 and 22 swap places, leading to the creation of an abnormal gene called BCR-ABL. This abnormal gene leads to the overproduction of white blood cells.
Symptoms of CML may include fatigue, unexplained weight loss, night sweats, and a sensation of fullness below the left ribs due to an enlarged spleen. It is often diagnosed following a blood test or bone marrow biopsy.
There are three different phases of CML: the chronic phase, the accelerated phase, and the blast phase. The chronic phase is typically the earliest phase and treatment is often most effective at this stage. As the disease progresses to the accelerated phase and then the blast phase, symptoms worsen and the cancer becomes more difficult to control.
The primary treatment for CML is targeted therapy with drugs called tyrosine kinase inhibitors (TKIs). These drugs block the activity of the BCR-ABL protein, and stop the overproduction of white blood cells.
Early diagnosis and treatment of CML can lead to remission and a normal life expectancy in many cases. However, some people may not respond to therapy or may lose their original response, requiring different approaches to treatment.
Treatment of Chronic myeloid leukaemia
Chronic Myeloid Leukaemia (CML) is a type of cancer that starts in certain blood-forming cells of the bone marrow. Here are some of the treatments generally used for CML:
1. Targeted Therapy: The first line of treatment is typically a type of targeted therapy called tyrosine kinase inhibitors (TKIs). TKIs work by blocking the effect of a protein made by the cancer cells that causes them to grow. The four TKIs approved by the FDA for initial treatment of CML are Imatinib (Gleevec), Dasatinib (Sprycel), Nilotinib (Tasigna), and Bosutinib (Bosulif).
2. Chemotherapy: If TKIs are not effective, treatment may involve chemotherapy. Chemotherapeutic drugs interfere with cell division processes, which can help control the growth of leukemia cells.
3. Stem Cell Transplant: High dose chemotherapy followed by stem cell transplant might be an option, especially for younger patients. This procedure involves destroying the cancerous bone marrow with high-dose chemotherapy, then infusing healthy stem cells (from a donor) into the body to replace the bone marrow.
4. Interferon: Interferon, which boosts the immune system, can be used but it often has severe side effects. It’s usually used during pregnancy (when TKIs are not advisable) or when other treatments have failed.
5. Clinical Trials: Patients can also participate in clinical trials for access to new therapies before they are widely available.
6. Supportive Care: This includes measures to help relieve the symptoms, such as pain and fatigue, but does not aim to treat the cancer itself.
Remember, each patient’s situation is different and treatment plans are individualized based on the patient’s overall health, the stage of the cancer and their tolerance for certain medications and therapies. It’s crucial that patients discuss their treatment options thoroughly with their healthcare team.
Please consult healthcare providers for personalized advice.
Medications commonly used for Chronic myeloid leukaemia
Chronic myeloid leukemia (CML) is often treated with targeted therapies which specifically target the cancer cells while minimising harm to normal cells. Here are several medications commonly used in treating chronic myeloid leukemia:
1. Tyrosine kinase inhibitors (TKIs): These are the main class of drugs used in the treatment of CML. They work by blocking the action of an abnormal enzyme (Bcr-Abl) that sends growth signals to the leukemia cells. This can help to stop the growth of the cancer cells. Types of TKIs include:
a. Imatinib (Gleevec): It was the first TKI developed and is typically the first line of treatment for CML.
b. Dasatinib (Sprycel): This is sometimes used as a first line of treatment, or for patients who can’t tolerate or have become resistant to imatinib.
c. Nilotinib (Tasigna): Like dasatinib, it’s used as a first line treatment or for those resistant to or intolerant of imatinib.
d. Bosutinib (Bosulif) and Ponatinib (Iclusig): These TKIs are often reserved for people who can’t tolerate or have become resistant to other TKIs.
2. Interferon: This is a drug that boosts the immune system and encourages healthy cells to grow and divide. It’s not used as much since TKIs were developed, but it can be used during pregnancy when TKIs are typically avoided.
3. Hydroxyurea (Hydrea): This chemotherapy drug might be used to temporarily control symptoms before definitive treatment with a TKI.
4. Corticosteroids: They are used to control the symptoms of CML during a very high white blood cell count phase (often referred to as a blast crisis).
5. Stem cell transplantation medication: Drugs may be used post-transplant to prevent the body from rejecting the new cells and to kill any remaining cancer cells.
As always, medications need to be tailored to the individual patient based on their condition, drug tolerance, and other factors.
Note: Always consult a doctor or a trained healthcare professional for specific treatments and medications. This list might not include all possible drugs or drug combinations for treating CML. It’s essential for patients to learn about the possible side effects of each medication and how they can be managed.
Prevention of Chronic myeloid leukaemia
Chronic Myeloid Leukaemia (CML) is a type of cancer that starts in certain blood-forming cells of the bone marrow. Genetic changes or mutations are primarily responsible for causing this disease. While it is not entirely possible to prevent CML due to its genetic nature, there are certain measures you can take to reduce the risk of chronic leukemias:
1. Avoid Exposure to Radiation: High exposure to radiation is one of the known risk factors for CML. So, reducing radiation exposure can potentially lower the risk.
2. Avoid Harmful Chemicals: Some studies show an association between exposure to certain chemicals used in industries like benzene and the risk of leukemia.
3. Healthy Lifestyle: Consuming a healthy diet, regular exercise, maintaining a healthy weight, and avoiding tobacco and alcohol can arguably lower the risk of developing various forms of cancer.
4. Regular Medical Checkup: Regular medical checkups aid in early detection which can enhance treatment outcomes.
Remember, these are broad measures to reduce the risk of cancers in general and are not guaranteed to prevent CML specifically. The biggest risk factors – age, gender, race/ethnicity, and certain genetic syndromes – are entirely out of one’s control.
FAQ’s about Chronic myeloid leukaemia
Chronic Myeloid Leukaemia (CML) is a type of cancer that starts in certain blood-forming cells of the bone marrow, leading to exponential growth of granulocytes; a subtype of white blood cells. Here are FAQs about CML:
1. What causes Chronic Myeloid Leukaemia (CML)?
The definitive cause of CML is unknown but it is linked with a genetic mutation called the Philadelphia chromosome. This chromosome creates a new gene, BCR-ABL, that produces an abnormal protein contributing to the growth of leukaemia cells.
2. What are the symptoms of CML?
CML usually develops gradually, with people noticing symptoms like fatigue, weight loss, frequent infections, easy bleeding or bruising, abdominal discomfort from an enlarged spleen, or a feeling of fullness even after eating a small portion of food.
3. Who is at risk for CML?
While the disease can occur at any age, it is most common in older adults. Exposure to high levels of radiation can also increase the risk of developing this disease.
4. How is CML diagnosed?
Doctors will typically do a complete blood count (CBC) to measure the number of each type of blood cell. They may also run tests such as a bone marrow biopsy, cytogenetic analysis or conduct a fluorescent in situ hybridization (FISH) to identify the Philadelphia chromosome.
5. How is CML treated?
CML is usually treated with targeted therapeutics called tyrosine kinase inhibitors (TKIs) which block the BCR-ABL protein produced by the Philadelphia chromosome. Other treatments include chemotherapy, stem cell transplant, or a combination of these.
6. Can CML be cured?
The goal of treatment in CML is to achieve a deep molecular response, that is, a significant reduction in or disappearance of the BCR-ABL gene in the blood. Although a cure for CML remains elusive, most people with this form of leukaemia can expect to have a normal or near-normal life span, as long as they continue to respond well to therapy.
7. Can CML turn into acute leukaemia?
While most cases of CML remain chronic, it can evolve into more advanced phases, such as ‘accelerated phase’ or ‘blast crisis’. In the ‘blast crisis’ phase, CML becomes more like an acute form of leukaemia with a rapid progression and short survival time.
Always consult a healthcare provider for diagnosis and treatment. This information is intended for general information and may not be applicable to everyone, as people can have varying symptoms and treatments options based on their individual situation.
Useful links
Chronic Myeloid Leukaemia (CML) is a type of cancer that starts in certain blood-forming cells of the bone marrow. In CML, a genetic change takes place in an early (immature) version of myeloid cells the cells that make red blood cells, platelets, and most types of white blood cells.
Here’s a list of relevant and useful medical journals and articles on chronic myeloid leukaemia:
Please consult a professional for personalized advice before making any decisions based on these articles.
Complications of Chronic myeloid leukaemia
Chronic myeloid leukaemia (CML) is a blood cancer where the body produces too many white blood cells. It’s a chronic condition, which means it lasts a long time and usually requires long-term treatment. Here are some of the potential complications of chronic myeloid leukaemia:
1. Blast Crisis: The most severe potential complication is the evolution of the disease into an aggressive acute leukaemia, known as a “blast crisis”. This stage of the disease is characterized by a rapid increase in white blood cell counts and the presence of immature blood cells, or blasts, in the blood.
2. Anemia: Chronic myeloid leukemia can cause anemia, a condition in which the number of red blood cells in your body is low. This can lead to fatigue, weakness, and shortness of breath.

3. Thrombocytopenia: Another complication is thrombocytopenia (low platelet count) which increases the risk of bleeding and bruising.
4. Splenomegaly: The excessive production of white blood cells can cause enlargement of the spleen (splenomegaly), which can cause discomfort or pain in the left upper abdomen.
5. Infections: Because CML affects the immune system, it can make you more susceptible to infections.
6. Side Effects from Treatment: The treatments for CML, such as tyrosine kinase inhibitors, may also cause side effects, including fluid retention, muscle cramps, nausea, diarrhea, rash, fatigue, etc.
7. Increased Risk of Other Cancers: People with CML have an increased risk of developing other cancers, including skin cancer and lymphoma.
8. Psychological Distress: Like other chronic illnesses, chronic myeloid leukemia can also cause significant emotional distress, anxiety, and depression.
Remember, the course of the disease and its complications vary significantly among individuals, and effective treatments are available that can mitigate many of these complications. Regular and careful follow-up with healthcare providers is important for people diagnosed with CML.
Home remedies of Chronic myeloid leukaemia
Chronic Myeloid Leukaemia (CML) is a serious condition that should always be diagnosed and treated by experienced healthcare professionals. It’s primarily managed by a type of medication known as tyrosine kinase inhibitors — drugs that block the cancer cells’ ability to reproduce and grow. This process is most effective when supervised by a doctor and usually can’t be effectively replaced by home remedies.
However, creating a healthy and supportive environment at home is an essential part of living with this disease, which can help maximize the effectiveness of medical treatment. Here are some home care tips:
1. Healthy Diet: Consuming a well-balanced diet filled with fruits, vegetables, lean proteins and whole grains can help strengthen the immune system and enable the body to better cope with the disease.
2. Regular Exercise: Regular physical activity can help improve energy levels and mood, and prevent or counteract side effects of treatment like fatigue and muscle weakness. Always consult with a doctor before starting any exercise program.
3. Hydration: It’s important to drink plenty of fluids to help the body’s organs function properly, including processing and flushing away the waste created by the treatment.
4. Adequate Rest: Getting enough sleep and relaxation is vital to the healing process. You should aim for at least 7-9 hours of sleep each night.
5. Limit Alcohol and Avoid Smoking: Both can weaken the immune system and make it more difficult for your body to fight off disease.
6. Emotional Support: Mental health is equally as important as physical health. Reach out to loved ones or trained professionals for emotional support.
Remember, these tips do not replace professional treatment for CML, and you should continue taking all prescribed medical therapies. Always consult with healthcare providers before making dietary changes, starting an exercise routine, or introducing other natural therapies into your regimen.